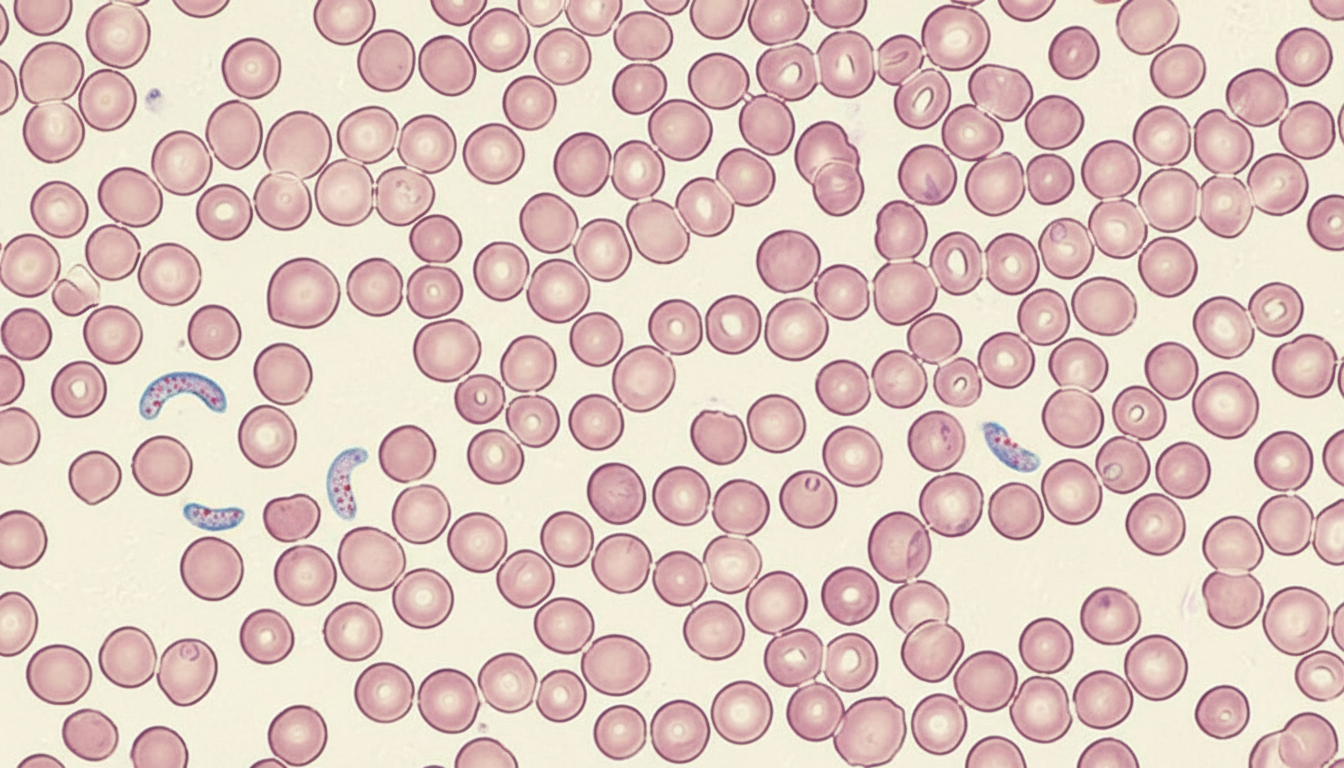
Image for question 749

Winterbottom's sign in sleeping sickness refers to:
Anchovy sauce pus is a feature of?
Which disease is transmitted by sandflies?
Paragonismus westermani is commonly called:
Which parasite is associated with Charcot-Layden crystals but lacks pus cells in its stain?
A child presents with nocturnal perianal pruritus and adult worms in the stool. What is the most common intestinal infection in school-age children globally?
In which host is the adult worm of Echinococcus typically found?
Cysticercosis cellulosae causes infection with which of the following?
A 15-year-old boy presented with fever and chills for the last 3 days. A peripheral blood smear revealed the following. Which of the following is the most probable causative agent?
Most fatal amoebic encephalitis is caused by which organism?
Explanation: **Explanation:** **Winterbottom’s sign** is a classic clinical hallmark of **African Trypanosomiasis** (Sleeping Sickness), specifically caused by *Trypanosoma brucei gambiense* (West African form). It refers to the visible and palpable swelling of the **posterior cervical lymph nodes**. This occurs during the hemolymphatic stage of the disease as the parasites disseminate through the lymphatic system, triggering a robust inflammatory response. **Analysis of Options:** * **Option A (Unilateral conjunctivitis):** This describes **Romana’s sign**, which is characteristic of **Chagas disease** (American Trypanosomiasis caused by *T. cruzi*), typically occurring when the parasite enters through the conjunctiva. * **Option C (Narcolepsy):** While sleeping sickness eventually leads to severe sleep-wake cycle disturbances (meningoencephalitic stage), "Winterbottom’s sign" specifically refers to the lymphadenopathy, not the neurological symptoms. * **Option D (Transient erythema):** Erythema marginatum or trypanosomal chancres may occur, but they are not synonymous with Winterbottom’s sign. **High-Yield Clinical Pearls for NEET-PG:** * **Vector:** Tsetse fly (*Glossina* species). * **Stages:** Stage I is Hemolymphatic (Winterbottom’s sign); Stage II is Neurological (Invasion of CNS leading to coma/death). * **Diagnosis:** Peripheral blood smear (C-shaped trypomastigotes) or lymph node aspirate. * **Kerandel’s Sign:** Deep hyperesthesia (exquisite pain after pressure on a nerve), another high-yield sign of the neurological stage. * **Treatment:** Pentamidine/Suramin (Stage I); Melarsoprol/Eflornithine (Stage II).
Explanation: **Explanation:** **Amebic liver abscess (ALA)**, caused by *Entamoeba histolytica*, is the most common extra-intestinal manifestation of amebiasis. The characteristic **"Anchovy sauce pus"** refers to the macroscopic appearance of the aspirated fluid. This occurs because the parasite causes **liquefactive necrosis** of hepatocytes. The resulting "pus" is not true inflammatory pus (which contains neutrophils) but rather a sterile collection of liquefied liver tissue, blood, and cellular debris, giving it a thick, chocolate-brown or reddish-brown appearance resembling anchovy paste. **Analysis of Incorrect Options:** * **Lung abscess:** Typically presents with foul-smelling, purulent sputum or aspirate, often containing pyogenic bacteria or anaerobes, but lacks the specific "anchovy sauce" consistency. * **Splenic abscess:** Usually results from hematogenous spread of infection (e.g., endocarditis). The aspirate is typically creamy yellow or greenish (pyogenic). * **Pancreatic abscess:** A complication of acute pancreatitis, characterized by infected peripancreatic fluid collections or necrotic debris, which does not follow the specific necrotic pattern of ALA. **Clinical Pearls for NEET-PG:** * **Location:** Most common in the **Right Lobe** of the liver (due to the bulk of blood flow from the superior mesenteric vein). * **Microscopy:** The pus itself is usually **sterile**; trophozoites are rarely found in the center of the abscess but are present in the **peripheral abscess wall**. * **Diagnosis:** Indirect Hemagglutination (IHA) is highly sensitive; Ultrasound shows a "shaggy" wall. * **Treatment:** Drug of choice is **Metronidazole** followed by a luminal amebicide (e.g., Diloxanide furoate).
Explanation: **Explanation:** The correct answer is **D. All of the above**. This question tests your knowledge of the medical importance of the **Sandfly** (*Phlebotomus* species), which serves as a biological vector for several distinct bacterial and protozoal diseases. 1. **Kala-azar (Visceral Leishmaniasis):** Caused by *Leishmania donovani*, this is the most significant disease transmitted by the sandfly. The parasite is transmitted to humans through the bite of an infected female *Phlebotomus argentipes*. 2. **Oriental Sore (Cutaneous Leishmaniasis):** Caused by *Leishmania tropica* and *Leishmania major*, this condition presents as self-limiting skin ulcers and is also transmitted via the sandfly bite. 3. **Oroya Fever (Bartonellosis):** This is the acute febrile stage of infection by the bacterium *Bartonella bacilliformis*. It is transmitted by the sandfly *Phlebotomus verrucarum* (primarily found in the Andes region of South America). **High-Yield Clinical Pearls for NEET-PG:** * **Vector Characteristics:** Sandflies are small, hairy flies that are "hop-fliers" and active at night. Only the **females** bite as they require a blood meal for egg production. * **Sandfly Fever (Pappataci Fever):** In addition to the options above, sandflies also transmit this viral disease caused by a Phlebovirus. * **Infective Stage:** For Leishmaniasis, the infective stage for humans is the **promastigote**, while the diagnostic stage in human tissue is the **amastigote** (LD bodies). * **Control:** Unlike mosquitoes, sandflies are highly sensitive to DDT, making indoor residual spraying an effective control measure.
Explanation: **Explanation:** *Paragonimus westermani* is the most common species of lung fluke causing human infection. It is a trematode (fluke) that primarily resides in the **parenchyma of the lungs**, where it lives in fibrous capsules. The infection, known as paragonimiasis, is typically acquired by consuming raw or undercooked crustaceans (crabs or crayfish) containing infective metacercariae. **Analysis of Options:** * **A. Lung fluke (Correct):** *P. westermani* is the definitive "lung fluke" because the adult worms migrate from the intestines, through the diaphragm, to settle in the lungs. * **B. Tapeworms:** These are Cestodes (e.g., *Taenia solium*, *Echinococcus*). They are segmented, ribbon-like worms, unlike the leaf-shaped, unsegmented flukes. * **C. Intestinal flukes:** This group includes *Fasciolopsis buski* and *Heterophyes heterophyes*, which reside in the small intestine. * **D. Liver flukes:** This group includes *Fasciola hepatica*, *Clonorchis sinensis*, and *Opisthorchis*, which primarily inhabit the bile ducts. **High-Yield Clinical Pearls for NEET-PG:** * **Infective Stage:** Metacercaria. * **Intermediate Hosts:** 1st—Snail (*Semisulcospira*); 2nd—Crab or Crayfish. * **Clinical Presentation:** Often mimics Pulmonary Tuberculosis (chronic cough, hemoptysis, and chest pain). * **Diagnosis:** Presence of operculated, golden-brown eggs in **sputum** or feces. Charcot-Leyden crystals are often seen in sputum. * **Drug of Choice:** Praziquantel.
Explanation: **Explanation:** The correct answer is **C. *Entamoeba histolytica***. The presence of **Charcot-Leyden crystals** in stool is a classic diagnostic marker for intestinal parasitosis. These diamond-shaped crystals are formed from the breakdown products of eosinophils (specifically the enzyme lysophospholipase). In **Amoebic dysentery** (*E. histolytica*), the stool is characterized by: 1. **Charcot-Leyden crystals:** Due to the eosinophilic response. 2. **Absence of Pus Cells (Neutrophils):** This is a high-yield distinction. *E. histolytica* produces a toxin called **amoebapore**, which lyses human neutrophils (pus cells) upon contact. Therefore, the microscopic examination shows "ghost cells" or cellular debris rather than intact pus cells, unlike bacillary dysentery (e.g., *Shigella*). **Analysis of Incorrect Options:** * **A. Giardia:** Causes malabsorption and steatorrhea (fatty stool). It is non-invasive and does not typically cause an eosinophilic or inflammatory response leading to these crystals. * **B. Taenia:** While helminthic infections can cause eosinophilia, *Taenia* (tapeworm) is usually diagnosed by identifying proglottids or eggs in stool; it does not typically present with the "no pus cell" dysenteric picture. * **D. Trichomonas:** This is a urogenital parasite. While it may cause discharge, it is not associated with stool findings or the specific crystal/pus cell paradox of amoebiasis. **NEET-PG High-Yield Pearls:** * **Amoebic Dysentery:** Stool is acidic, contains RBCs in clumps (rouleaux), and lacks pus cells. * **Bacillary Dysentery:** Stool is alkaline, contains numerous pus cells (neutrophils), and lacks Charcot-Leyden crystals. * **Trophozoite of *E. histolytica*:** Look for ingested RBCs (erythrophagocytosis), which is pathognomonic for invasive disease.
Explanation: **Explanation:** The clinical presentation of **nocturnal perianal pruritus** (itchy bottom at night) in a school-age child is the classic hallmark of **Enterobius vermicularis** (Pinworm/Threadworm) infection. **Why Enterobius vermicularis is correct:** Enterobius vermicularis is the **most common helminthic infection** worldwide, particularly among school-aged children. The pathogenesis involves the gravid female worm migrating out of the anus at night to deposit eggs on the perianal skin. This causes intense irritation (pruritus ani), leading to scratching and subsequent **autoinoculation** or transmission via contaminated fingers and fomites. Diagnosis is typically made using the **NIH swab** or **Scotch tape test** to detect eggs. **Why the other options are incorrect:** * **Plasmodium vivax:** This is a protozoan parasite causing malaria. It is a systemic infection transmitted by mosquitoes, not an intestinal infection presenting with perianal itching. * **Entamoeba histolytica:** This causes amoebic dysentery. While common, it typically presents with bloody diarrhea and abdominal pain rather than perianal pruritus. * **Strongyloides stercoralis:** Known for causing "larva currens" and autoinfection, it is less common than Enterobius in the general school-age population and usually presents with abdominal symptoms or respiratory signs (Loeffler’s syndrome). **High-Yield NEET-PG Pearls:** * **Drug of Choice:** Albendazole or Mebendazole (treat the **entire family** to prevent reinfection). * **Diagnostic Test of Choice:** Scotch tape test (performed early morning before bathing). * **Key Feature:** Eggs are non-bile stained and have a characteristic **D-shape** (flattened on one side). * **Retroinfection:** Occurs when larvae hatch on the perianal skin and migrate back into the colon.
Explanation: ### Explanation **Correct Option: A (Dog)** *Echinococcus granulosus* (the dog tapeworm) follows a life cycle involving a **definitive host** and an **intermediate host**. By definition, the **adult worm** resides in the small intestine of the definitive host, which is the **Dog** (or other canines like wolves and foxes). The adult worm is small (3–6 mm) and does not cause significant disease in the dog. **Why Incorrect Options are Wrong:** * **B. Human:** Humans serve as **accidental intermediate hosts**. In humans, the parasite exists only in the **larval stage** (metacestode), which develops into a **Hydatid cyst**, typically in the liver or lungs. Humans are a "dead-end" for the parasite. * **C. Domestic animals:** Animals like sheep, cattle, and goats are the **natural intermediate hosts**. Like humans, they harbor the **larval stage** (Hydatid cyst) after ingesting eggs. The cycle is completed when a dog eats the viscera of these animals containing the cysts. * **D. Feline:** Cats are generally refractory to infection with *E. granulosus* and do not play a significant role in its life cycle. **NEET-PG High-Yield Pearls:** 1. **Infective Stage for Humans:** Embryonated eggs (found in dog feces). 2. **Diagnostic Feature:** "Hydatid sand" (contains brood capsules and protoscolices) found within the cyst fluid. 3. **Casoni Test:** An immediate hypersensitivity skin test (now largely replaced by ELISA and imaging). 4. **Radiology:** Look for the **"Water Lily Sign"** (collapsed germinal membrane) on ultrasound/CT. 5. **Treatment:** PAIR (Puncture, Aspiration, Injection, Re-aspiration) technique and Albendazole. Never biopsy a suspected cyst due to the risk of **anaphylaxis** from fluid leakage.
Explanation: **Explanation:** **Cysticercosis cellulosae** is the larval stage of **_Taenia solium_** (Pork tapeworm). In the normal life cycle, humans are the definitive hosts (harboring the adult worm) and pigs are the intermediate hosts (harboring the larvae). However, humans can become accidental intermediate hosts by ingesting _T. solium_ eggs through contaminated food/water or autoinfection. Once ingested, the oncospheres hatch, penetrate the intestinal wall, and disseminate to various tissues (brain, muscles, eyes) to form **Cysticercus cellulosae**. **Analysis of Options:** * **Taenia saginata (Beef tapeworm):** Its larval stage is called *Cysticercus bovis*, found in cattle. Importantly, *T. saginata* does **not** cause cysticercosis in humans because the eggs are not infectious to man. * **Echinococcus granulosus (Dog tapeworm):** This parasite causes **Hydatid disease**. The larval stage is the Hydatid cyst, typically found in the liver or lungs. * **Diphyllobothrium latum (Fish tapeworm):** The larval stages are the procercoid and plerocercoid (sparganum). It is clinically associated with Vitamin B12 deficiency and megaloblastic anemia. **NEET-PG High-Yield Pearls:** * **Neurocysticercosis (NCC):** The most common cause of adult-onset seizures in developing countries. On CT/MRI, it presents with "starry sky" appearance (multiple calcified cysts) or a "hole-with-dot" appearance (scolex inside the cyst). * **Infective Stage:** For intestinal taeniasis, it is the *Cysticercus cellulosae* (in undercooked pork); for cysticercosis, it is the **egg** of _T. solium_. * **Drug of Choice:** Albendazole is the preferred cysticidal agent; Praziquantel is an alternative. Steroids are added to manage inflammation caused by dying larvae.
Explanation: ***Plasmodium falciparum*** - **Multiple ring forms per RBC** and **appliqué/accolé forms** (rings positioned at the periphery of RBCs) are pathognomonic for P. falciparum on peripheral smear. - **Small delicate rings** with **crescent/banana-shaped gametocytes** and absence of enlarged RBCs distinguish it from other species, making it the most dangerous malaria parasite causing **cerebral malaria**. *Plasmodium malariae* - Shows **thick band forms** and **rosette schizonts** with 6-12 merozoites arranged around central pigment, not multiple rings per RBC. - Has a **72-hour fever cycle** (quartan malaria) and typically shows **single ring forms** per infected RBC. *Plasmodium ovale* - Characterized by **oval-shaped infected RBCs** with **fimbriated edges** and **Schüffner's dots** in the cytoplasm. - Shows **enlarged RBCs** and **compact ring forms**, unlike the small delicate rings seen in P. falciparum. *Plasmodium vivax* - Distinguished by **enlarged pale RBCs** with **Schüffner's dots** and **amoeboid trophozoites** that fill most of the RBC. - Shows **single ring forms** per RBC and **round gametocytes**, contrasting with P. falciparum's multiple rings and crescent gametocytes.
Explanation: **Explanation:** The correct answer is **Naegleria fowleri**, the causative agent of **Primary Amoebic Meningoencephalitis (PAM)**. **1. Why Naegleria is correct:** *Naegleria fowleri*, often called the "brain-eating amoeba," causes an acute, fulminant, and almost universally fatal infection of the Central Nervous System. It typically affects healthy children or young adults with a history of swimming in warm freshwater. The amoeba enters via the **nasal mucosa**, penetrates the **cribriform plate**, and migrates along the olfactory nerves to the brain. Death usually occurs within 7–10 days due to rapid brain tissue destruction and edema. **2. Why other options are incorrect:** * **Entamoeba histolytica:** While it can cause brain abscesses (secondary to hepatic or pulmonary involvement), it is primarily an intestinal pathogen causing amoebic dysentery and liver abscesses. It does not cause primary encephalitis. * **Entamoeba dispar:** This is a non-pathogenic commensal morphologically identical to *E. histolytica* but does not cause invasive disease. * **Acanthamoeba:** This organism causes **Granulomatous Amoebic Encephalitis (GAE)**. Unlike the acute course of *Naegleria*, GAE is a **chronic/subacute** infection occurring primarily in immunocompromised individuals. While serious, it is not as rapidly fatal as PAM. **High-Yield Clinical Pearls for NEET-PG:** * **Habitat:** Warm freshwater, swimming pools, and thermal springs. * **Diagnostic Finding:** Presence of **actively motile trophozoites** in a wet mount of CSF (Note: Cysts are never found in brain tissue/CSF for *Naegleria*). * **Drug of Choice:** Amphotericin B (often used in combination with Miltefosine). * **Key Differentiator:** *Naegleria* = Acute, healthy host, nasal route; *Acanthamoeba* = Chronic, immunocompromised host, skin/lung route.
Classification of Parasites
Practice Questions
Intestinal Protozoa
Practice Questions
Blood and Tissue Protozoa
Practice Questions
Malaria Parasites
Practice Questions
Leishmaniasis
Practice Questions
Intestinal Helminths: Nematodes
Practice Questions
Tissue Nematodes
Practice Questions
Trematodes
Practice Questions
Cestodes
Practice Questions
Ectoparasites
Practice Questions
Antiparasitic Drugs
Practice Questions
Laboratory Diagnosis of Parasitic Infections
Practice Questions
Get full access to all questions, explanations, and performance tracking.
Start For Free